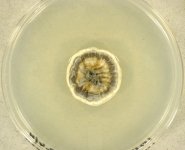

Search Details
| UAMH Number: | 10112 |
|---|---|
| Species Name: | Hyaloscypha sp. |
| Type: | |
| Synonyms: | Candelabrum / Eupezizella / Fuscoscypha / Meliniomyces / Parorbiliopsis / Pseudaegerita / Rhizoscyphus / Truncicola |
| Taxonomy: | FUNGI Ascomycota, Leotiomycetes, Helotiales, Hyaloscyphaceae |
| Strain History: | Vralstad, T. (ARON 2917.S) -> UAMH |
| Substrate: | as morphotype Piceirhiza bicolorata;, roots of birch (Betula pubescens) seedling (#32) from 5 yr clear-cut spruce forest | Location: | NORWAY Akershus, Eidsvoll (GEO: 60.33,11.272) |
| Isolator: | T. Vralstad |
| Isolation Date: | 1998 |
| Date Received: | 2001-12-14 |
| Characters: | CULTURE CONDITIONS colony detaches from cellophane overlaid on PDA - // CULTURE CONDITIONS dark grey & light sectors - // MOLECULAR SYSTEMATICS G2 isolate - // MOLECULAR SYSTEMATICS Hymenoscyphus ericae aggregate subclade 4, ITS1 genotype G2, morphology group 3 - Vralstad, Fossheim & Schumacher, New Phytol. 145:549-563, 2000 // MOLECULAR SYSTEMATICS Hymenoscyphus ericae aggregate subclade 4, ITS1 genotype G2, morphology group 3 - Vralstad, Ph.D. Dissertation, 2001 // MOLECULAR SYSTEMATICS Hymenoscyphus ericae aggregate subclade 4, ITS1 genotype G2, morphology group 3 - Vralstad, Schumacher & Taylor, New Phytol. 153:143-152, 2002 // MOLECULAR SYSTEMATICS phylogenetic relationships within the Rhizoscyphus ericae (Hymenoscyphus ericae) aggregate - Hambleton S, Sigler L, Stud. Mycol. 53:1-27, 2005 // MOLECULAR SYSTEMATICS relationship with Piceirhiza bicolorata ectomycorrhizal mycobionts - Vralstad, Myhre & Schumacher, New Phytol. 155:131-148, 2002 // MYCORRHIZAE ectomycorrhizal in inoculation trials - Vralstad, Schumacher & Taylor, New Phytol. 153:143-152, 2002 // MYCORRHIZAE mycobiont of Piceirhiza bicolorata ectomycorrhizal morphotype - Vralstad, Fossheim & Schumacher, New Phytol. 145:549-563, 2000 (Click for publications citing UAMH 10112) |
| Compounds: | |
| Cross Reference: | ARON 2917.S // CBS 116127 // G2 // UDB000506 |
| Collections: | Living Strains; Dried Herbarium Material |
| Pathogenic Potential: | Human: no | Animal: no | Plant: yes |
| Biosafety Risk Group: | RG1 (check the PHAC ePATHogen Risk Group Database for updates) |
| Regulatory Requirements: | Canadian requesters must provide PHAC Pathogen and Toxin License Number (see: https://www.canada.ca/en/public-health/services/laboratory-biosafety-biosecurity/licensing-program.html) prior to shipment. International requesters must provide all legally required importation documentation prior to shipment. Plant pathogenicity status may be verified by using the USDA Agricultural Research Service (ARS) Fungal Database |
| MycoBank ID: | 2392 |
| Sequences: | >UAMH10112_AJ243548_ITS TATTCCCAAACCGTGTATACATATCTTTGTTGCTTTGGCGGGCCGCCTTCGGGCGTTGGCTCCGGCTGATTGCGCCCGCCAGAGGACCCAAACTCGTTTGTTTAGTGATGTCTGAGTACCATATAATAGTTTAA >UAMH10112_UAMH_ITS CATTAAAGAATCGCCCCGTTTTTTGAAATGGGTTCTATTCCCAAACCGTGTATACATATCTTTGTTGCTTTGGCGGGCCGCCTTCGGGCGTTGGCTCCGGCTGATTGCGCCCGCCAGAGGACCCAAACTCGTTTGTTTAGTGATGTCTGAGTACCATATAATAGTTTAAAACTTTCAACAACGGATCTCTTGGTTCTGGCATCGATGAAGAACGCAGCGAAATGCGATAAGTAATGTGAATTGCAGAATTCAGTGAATCATCGAATCTTTGAACGCACATTGCGCCCTTTGGTATTCCGAGGGGCATGCCTGTTCGAGCGTCATTATAACCACTCAAGCCTTGGCTTGGTATTGGGGTTCGCGGTTTCGCGGCTCTTAAAATCAGTGGCGGTGCCGTCTGGCTCTAAGCGTAGTAATTTTTCTCGCTATAGGGTCCCGGTGGTGGCTTGCCAAAACCCCCCTT >UAMH10112_AJ292200_SSU CATTAAAGAATGCCCCGTTTTTCGAAACGGGTTCTATTCCCAAACCGTGTATACATACCTTTGTTGCTTTGGCGGGCCGCCTTCGGGCGTTGGCTCCGGCTGATTGCGCCCGCCAGAGGACCCAAACTCGTTTGTTTAGTGATGTCTGAGTACCATATAATAGTTTAAAACTTTCAACAACGGATCTCTTGGTTCTGGCATCGATGAAGAACGCAGCGAAATGCGATAAGTAATGTGAATTGCAGAATTCAGTGAATCATCGAATCTTTGAACGCACATTGCGCCCTTTGGTATTCCGAGGGGCATGCCTGTTCGAGCGTCATTATAACCACTCAAGCCTTGGCTTGGTATTGGGGTTCGCGGTTTCGCGGCTCTTAAAATCAGTGGCGGTGCCGTCTGGCTCTAAGCGTAGTAATTTTTCTCGCTATAGGGTCCCGGTGGTGGCTTGCCAAAACCCCCCTTATTTTCCTACGGTTGA |
IMAGES: